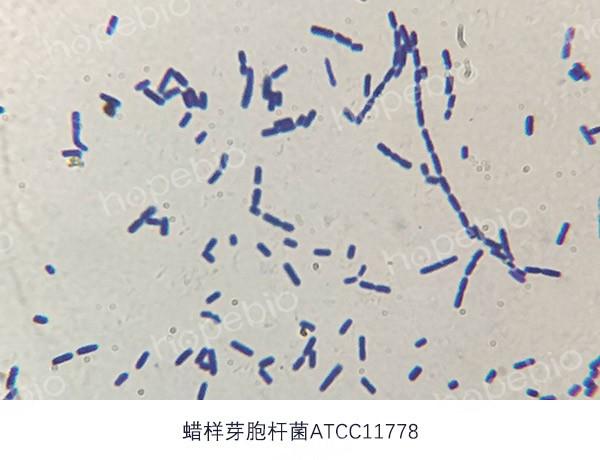

一罐问题奶粉,掀起了全球食品安全的波澜。当跨国巨头雀巢紧急召回的消息传来,中国父母们的心又一次被揪紧了。
2026年元旦刚过,一则来自瑞士的公告让全球父母心头一紧。雀巢公司宣布,在全球31个国家和地区召回部分批次的婴幼儿配方奶粉。
中国市场上的力多精、铂初能恩、舒宜能恩、惠氏膳儿加等4个品牌30个批次产品也同步启动回收。国务院食安办、市场监管总局迅速介入,督促雀巢做好召回工作。

---
01 事件引爆
这场全球性召回始于雀巢公司对原料的严格自查。在对用于生产婴幼儿配方奶粉的花生四烯酸油及相关油脂混合物进行检测时,雀巢发现供应商提供的这种油脂原料存在质量问题。
问题原料中可能存在蜡样芽孢杆菌,这种细菌可能引起食源性疾病。英国食品标准局指出,这种细菌具有高度热稳定性,即使在烹饪、使用沸水或冲调婴儿奶粉的过程中也不太可能被灭活或破坏。
值得警惕的是,截至1月8日,雀巢的ARA产品供应商嘉必优表示“相关原料在检测中,尚未出结果”。这家总部位于武汉的生物技术公司,是国内ARA领域的重要供应商。
02 中国市场
雀巢中国迅速作出反应,对中国市场少数可能受影响的产品启动预防性回收。具体涉及中国大陆线下渠道的4大品牌共30个批次产品,以及跨境电商渠道的41个批次进口产品。
根据雀巢中国官网发布的“预防性自愿回收婴幼儿配方奶粉”公告,需要召回的产品批次已在官网公布。公司强调,此次召回范围之外的所有其他雀巢产品及同类产品的其他批次均可安全食用。
雀巢中国特别指出,所有在中国大陆市场注册并销售的雀巢特殊医学用途婴儿配方食品、超启能恩、启赋、S26铂臻等不受影响。
03 官方回应
国务院食安办、市场监管总局对此事高度重视,第一时间督促雀巢(中国)有限公司认真落实企业主体责任。两部门明确要求雀巢召回在中国境内销售的相关批次产品,切实维护消费者合法权益。
监管部门的快速反应显示了政府对婴幼儿配方乳粉质量安全的高度重视。两部门表示将持续强化监管,做好相关工作,全力保障婴幼儿配方乳粉质量安全。
雀巢公司表示,此次全球召回涉及的奶粉批次占集团年销售额的比例远低于0.5%,预计此次召回对集团的财务影响不会很大。
04 供应链冲击
此次召回事件的焦点指向了花生四烯酸油的供应商。全球能规模化生产ARA的企业屈指可数,当其中一家出现系统性偏差,便会瞬间放大为行业性危机。
嘉必优作为雀巢的ARA供应商之一,在此次事件中备受关注。该公司证券部相关负责人1月7日表示:“我们正联系相关的检测机构,包括监管部门,来做产品检测,现在尚未出结果。”
资本市场反应迅速。截至1月8日收盘,嘉必优股价大跌11.91%,报21.15元/股。这家公司在国内ARA领域市场占有率超过50%,此次事件无疑对其市场信誉造成了冲击。
05 行业波及
雀巢奶粉召回事件引发了整个婴幼儿配方奶粉行业的连锁反应。达能中国1月8日迅速回应称,其所有官方进口的婴幼儿配方奶粉均未使用雀巢涉事供应商的ARA原料。
美赞臣中国也紧随其后回应媒体,表示美赞臣中国与近期召回事件中的供应商不存在ARA原料供应合作关系。两大奶粉巨头的快速澄清,旨在消除消费者的疑虑。
业内专家指出,此次事件凸显了婴幼儿配方奶粉行业供应链管理的重要性。ARA是促进婴幼儿大脑和神经系统发育的关键脂肪酸,是高端婴幼儿配方奶粉中的常见添加成分。
06 应对指南
全面检查批次:立即核对家中奶粉罐底部的批次信息,与雀巢中国官网公布的召回批次进行比对。
正确处置产品:如发现家中奶粉属于召回批次,请立即停止使用,并联系购买渠道或雀巢客服进行退货处理。
关注宝宝状态:蜡样芽孢杆菌中毒症状可能迅速出现,包括恶心、呕吐、胃部痉挛等。如宝宝出现不适,应及时就医。
保持理性态度:此次召回是预防性措施,截至目前尚未收到与相关产品有关的任何不适报告。不必过度恐慌,但需认真对待。
07 行业反思
乳业专家宋亮认为,预防式召回是企业对消费者负责任的态度。他指出,企业必须跳出“合规即安全”的思维,建立“非必检菌种”的主动监测与风险评估机制。
此次事件也凸显了全球化供应链的风险管理挑战。当关键原料由少数几家企业供应时,任何一家的质量问题都可能波及整个行业。
随着新国标对DHA和ARA等营养素的添加要求更加明确,如何确保这些高附加值营养素的安全稳定供应,成为整个行业必须面对的课题。

---
雀巢此次全球性召回如同一面镜子,既照见了企业对食品安全底线的坚守,也反映出全球化供应链中原料安全的脆弱性。
对于父母而言,核对奶粉批次编号已成为这个冬天的必要动作;对于行业来说,这场风波或许将推动更严格的原料检测标准和供应链透明度改革。
你家宝宝喝过这些批次的奶粉吗?对于婴幼儿食品安全,你有什么建议或担忧?欢迎在评论区分享你的观点!